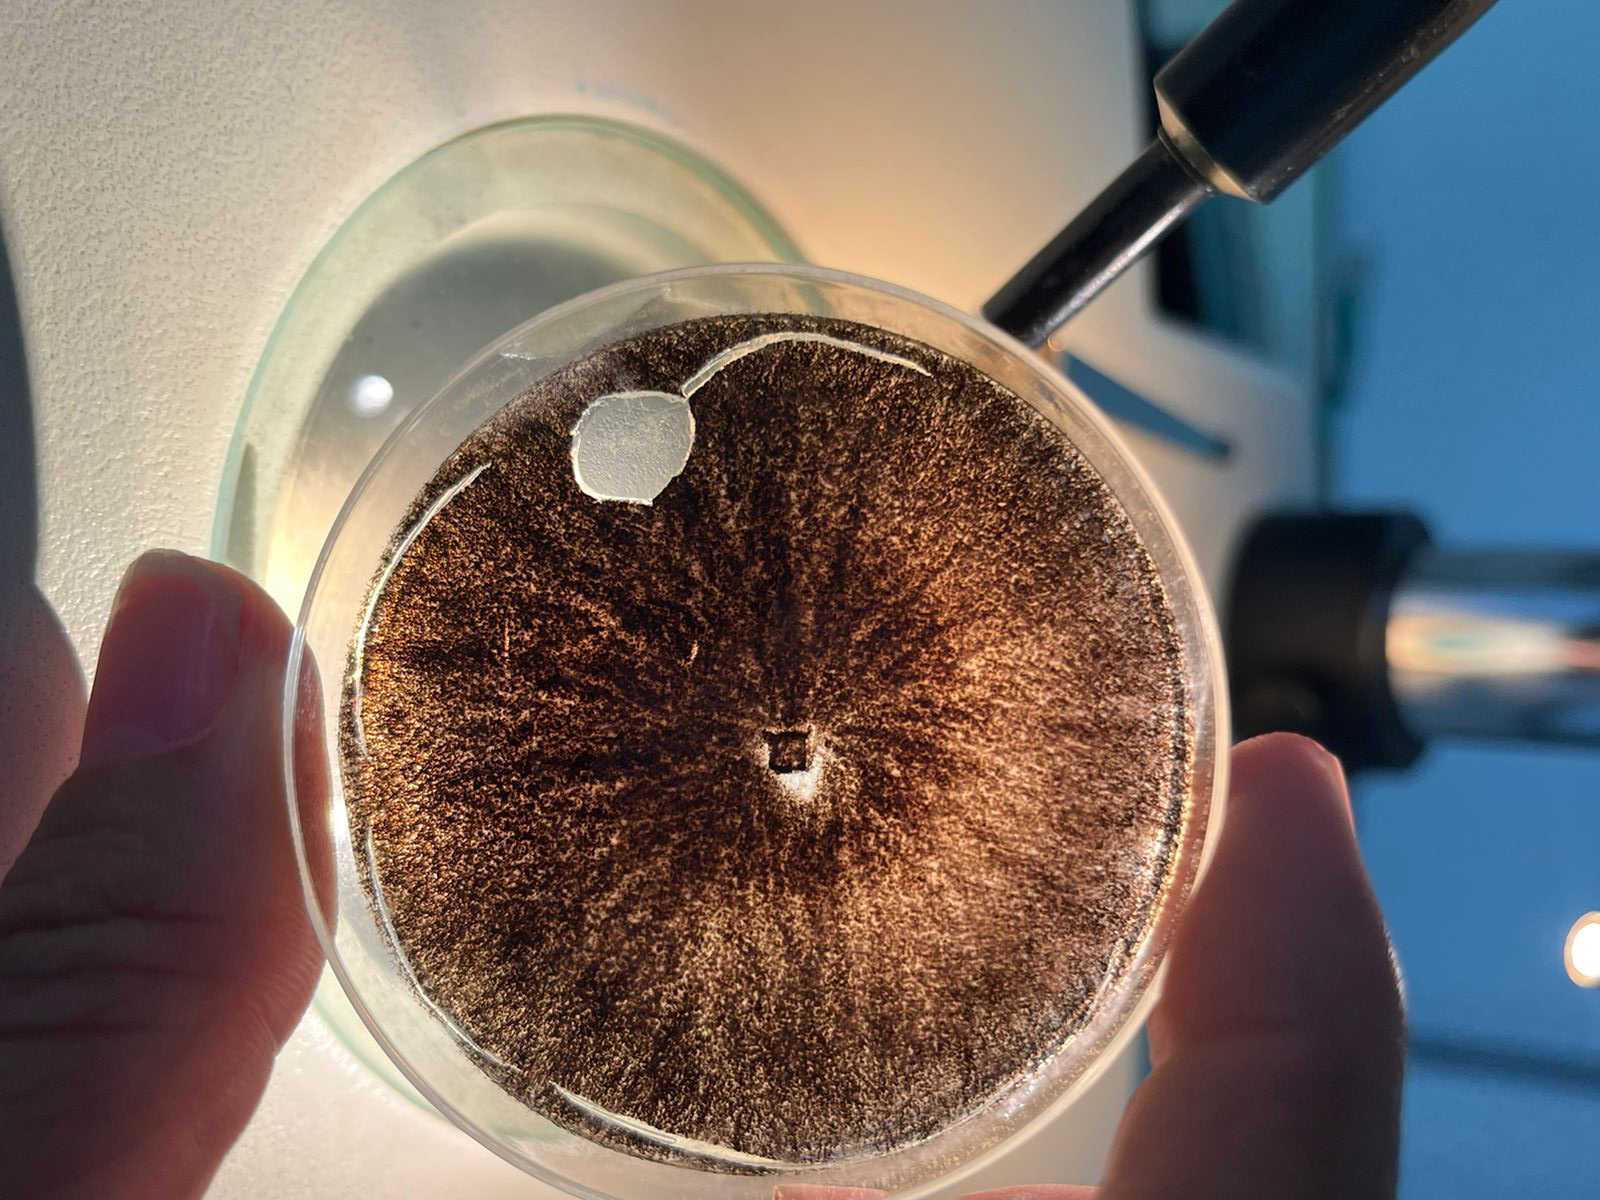

Análise de Fungos e Nematoides
A análise de fungos e nematoides é uma ferramenta essencial para identificar agentes patogênicos ou benéficos no solo, nas plantas e em ambientes agrícolas. Essa prática auxilia no monitoramento e manejo eficiente, promovendo:
- Identificação de espécies desses patógenos;
- Controle de doenças e perdas agrícolas;
- Melhora na saúde do solo e das plantas;
- Aumento da produtividade e sustentabilidade do cultivo.
Por que realizar a análise de fungos?
- Identificação precisa de fungos e nematoides patogênicos e benéficos;
- Controle preventivo de doenças causadas por fungos e nematoides, reduzindo impactos negativos na lavoura;
- Planejamento estratégico para aplicação de defensivos agrícolas e produtos biológicos;
- Melhora da qualidade do solo, promovendo equilíbrio microbiológico;
- Redução de custos, ao evitar perdas por doenças e minimizar aplicações desnecessárias de produtos.
Finalidades da análise de fungos
- Identificação de patógenos: Detecção de fungos e nematoides causadores de doenças como fusariose, antracnose, podridões radiculares, entre outros.
- Monitoramento de fungos benéficos: Avaliação de organismos que promovem a saúde do solo, como trichoderma.
- Diagnóstico de doenças: Identificação de problemas fúngicos em plantas para manejo adequado.
- Controle microbiológico: Análise para desenvolvimento de estratégias de controle biológico de fungos e nematoides prejudiciais.
- Estudos ambientais: Monitoramento de fungos em ambientes agrícolas para melhorar práticas sustentáveis.
Entre em contato e saiba mais como podemos ajudar!
- (16) 3403-9857
- (16) 99948-2686
Com a 2ML Análises Agrícolas, você garante eficiência e resultados precisos.
CONTATO
Rua Antonio Olavo Ferro, 2210
Polo Industrial Amazonas
14406-056 – Franca – SP
(16) 3403-9857 e (16) 99948-2686

